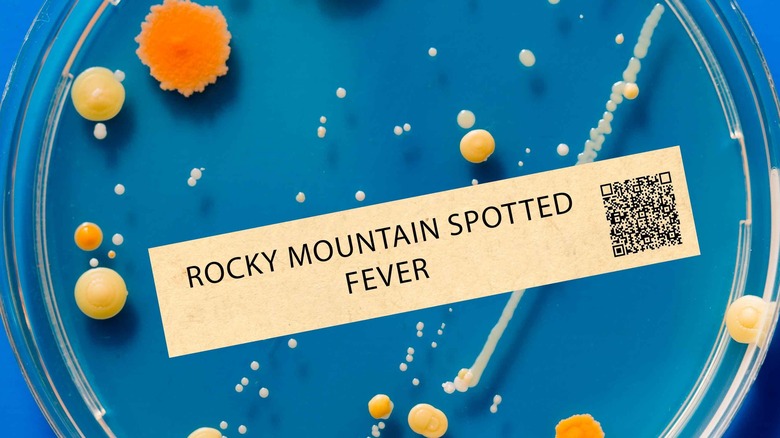

12 Dangerous Diseases Spread By Ticks You Need To Be Aware Of
Ticks are among the most reviled creatures on the planet. They are second only to mosquitoes in terms of their propensity to annoy everyone they come into contact with. A member of the arachnid family, which makes them cousins of the spider, ticks have the unique ability to pass along some dangerous diseases to whoever or whatever they bite. While a lot depends on the type of tick and how long it's attached, all have the capability to carry disease.
Despite all the safety efforts you might take to avoid a tick bite, chances are you'll be bitten at least once. And when you are, you need to take it seriously. Ticks remain alive by feasting on the blood of a host. If one host is carrying some blood-borne pathogen, the tick will ingest that pathogen and carry it on to the next host. The process continues with each successive host.
The diseases on this list all have the potential to be dangerous, some even life threatening. While some of the diseases are rarer than others, everyone should be cautious whenever it comes to handling tick bites. If you experience any of the symptoms henceforth described, seek medical attention immediately.
Lyme disease
No disease is more commonly associated with ticks than Lyme disease. In fact, Lyme is the top reported tick-borne disease in the United States, per the CDC. Caused by the Borrelia bacteria, Lyme disease occurs in successive worsening stages. According to the Mayo Clinic, the disease first appears as a classic bulls-eye rash, followed by fever, headache, exhaustion, swollen lymph nodes, and stiff joints.
Lyme can then progress into increasing severity if it isn't treated promptly. At Stage 2, the rashes will get worse, joint and muscle pain will increase, and the immune system will begin to deteriorate, potentially causing irregular heartbeat and even blindness. The final stage of Lyme is called dissemination, meaning that the disease is there to stay. Though the effects will come and go, the muscle stiffness and other symptoms will be with you forever. Death via Lyme is extremely rare.
Lyme disease is passed along to humans via the black-legged tick, also known as the deer tick. These are highly common ticks found throughout the eastern and midwestern United States. Commonly no larger than a sesame seed when fully grown, adult black-legged ticks are defined by their spindly legs and reddish abdomens. Not all carry Lyme disease, but if your bite begins to develop a bullseye within a few days of being bit, contact your doctor immediately.
Anaplasmosis
Not nearly as common as Lyme disease, Anaplasmosis is nevertheless another bacterial infection that can have serious ramifications if not treated properly. Anaplasmosis has the potential to be fatal. Though this is less than a 1% likelihood, according to the CDC, people with compromised immune systems, of advanced age, or with pre-existing conditions are at higher risk of fatality if infected by Anaplasmosis.
Originally known as Human Granulocytic Ehrlichiosis (HGE), Anaplasmosis is passed to people by the same black-legged ticks that cause Lyme disease. Not all black-legged ticks carry Anaplasmosis, but caution needs to be taken if a bite is noticed. Symptoms for Anaplasmosis appear within a 1-2 week period. However, the bacterium can only be passed along if the tick is attached for more than 12 hours.
Common signs and symptoms of Anaplasmosis include fatigue, headache, muscle pain, and chills. Less common symptoms include nausea and vomiting, respiratory failure, abdominal pain, and altered mental status. Another disease endemic to the midwest and eastern United States, Anaplasmosis can be treated with antibiotics if caught early enough.
Babesiosis
Another disease passed along by the black-legged tick, Babesiosis can sound somewhat scary to the potentially infected. According to the CDC, the disease is caused by microscopic parasites that enter the bloodstream via the tick bite. These parasites, known as Babesia, already exist within the human body and cause no harm. However, Babesia microti are the red blood cell-attacking parasites that cause this disease.
Those with removed spleens, compromised immune systems, or those with cancer or HIV are at higher risk of death when infected with Babesiosis. Though severe infections are highly uncommon, Babesiosis presents itself in a number of different symptoms, including high fever, muscle aches, chills, fatigue, and anemia. Most cases will clear up on their own without the need for treatment. If the infection is severe enough, however, hospitalization is required.
The interesting thing about Babesosis transmission is that you might not even know that you've been bitten by a carrying tick. This is because only nymph-stage ticks can pass it along. Ticks are so small at this point in their lives that a bite will likely go unnoticed. Found during the warm months in tall grass and wooded environments, nymph ticks can easily attach themselves without a host's knowledge.
Colorado tick fever
Noted by their brown coloration and larger size Rocky Mountain Wood ticks have a habitable range across several with elevations over 4,000 feet. This includes the U.S. states of Idaho, Washington, Oregon, Wyoming, Nevada, Colorado, Utah, and Montana, and parts of southwestern Canada. Adult Rocky Mountain Wood ticks are capable of passing on a number of different diseases to people, one of which is Colorado Tick Fever (CTF).
Unlike bacterial tick-borne diseases, CTF is a virus. This means that treating the disease with antibiotics is useless, as antibiotics only attack bacteria. Though many cases can clear up with several days of rest and plenty of fluids, more severe cases will require hospitalization. The best way to prevent CTF is to take preventative measures towards not being bitten in the first place.
If CTF occurs, symptoms will include high fever, chills, headache, body aches, nausea, and potential skin rash. The Wyoming Department of Health also states that CTF is often biphasic, meaning that a bitten person will experience a primary fever, have a brief recovery period, and then relapse into a secondary fever. The weakness and fatigue caused by CTF can last for several weeks.
Heartland virus
According to the Cleveland Clinic, the first case of Heartland disease to appear in the United States was in Missouri in 2009. Whether this led to the virus being called the Heartland is unknown, but quite likely. It is an exceptionally rare viral disease; only 60 cases have been reported since the primary in 2009. As it is a relatively new virus, not much is known about its origins, including how many species of tick carry it.
The Lone Star tick is believed to be the primary transmitter of Heartland virus. Found in the very states that have reported cases of the disease, the Lone Star tick is distinguished by a single white spot on its otherwise orange-brown abdomen. Though they are the only known species to spread this disease, it's believed it can be passed on by numerous types of ticks and even mosquitoes.
Symptoms for Heartland virus are similar to others on this list. Fever, headache, sore muscles, cramping, and vomiting are all common. Mild cases can last up to a few weeks, with more severe ones lasting months. Nearly all reported cases have ended at hospitals with IV intervention for fluid intake and have included several secondary symptoms like loss of appetite. There is currently no known treatment for the Heartland virus.
Rocky Mountain spotted fever
Not as rare as the Heartland virus and not as common as Lyme disease, Rocky Mountain Spotted fever remains a known tick-borne illness in spite of its low caseload. A disease that affects only around 2,000 people per year, per Johns Hopkins Medicine, the illness was borne out of the Rocky Mountains and is passed along by the Rocky Mountain wood tick. Though most cases of the disease occur out west, cases have spread as far east as New York and Maine, where it is spread by Dog ticks.
The fever gets its name from the pink splotches that appear on the body after infection. These typically appear within 5 to 10 days of being bitten. It is imperative to seek treatment as soon as the rashes appear. According to the New York Department of Health, even previously healthy people are capable of dying within that 5 to 10-day splotch window.
Other symptoms are nausea, vomiting, loss of appetite, fatigue, sore throat, and light sensitivity. Treatment can be had with antibiotics, but those who do not seek it run the risk not only of death but of lasting damage to their bodies. Nerve damage, hearing loss, partial paralysis, and even loss of toes or fingers are possible.
Powassan virus disease
Powassan Virus disease is rare, with only 100 cases reported within the last 10 years, 16 of which occurred in the Commonwealth of Massachusetts, via Mass.gov. Despite this rarity, the Powassan virus has the potential to be extremely serious. Passed along, once again, by the black-legged tick, the Powassan virus is most likely transmitted during the spring and summer when ticks are most active.
Symptoms are usually mild for most who end up getting infected. They tend to show up within a week of being bitten, though they can sometimes present themselves after a month or two. The mild version of a Powassan infection includes several flu-like symptoms, including fever, headache, muscle aches, and abdominal cramping.
Severe cases of the Powassan virus are extremely dangerous. The virus has the potential to cause additional damage by causing harmful diseases like meningitis, which inflames the membranes of the brain and the spinal cord, and encephalitis, which inflames the actual brain muscle. Both of these diseases are deadly, which is why you should seek immediate treatment if your Powassan symptoms don't clear up within a week.
Ehrlichiosis
Another bacterial infection whose severity depends upon the health of the host, Ehrlichiosis occurs primarily in the warmer months when ticks are most active. The disease has a wide range, with cases being reported across the midwest, southern, and eastern United States. The primary cause of the disease is the Ehrlichia chaffeensis bacteria which is commonly found in white-tailed deer. The primary spreader of said bacteria is none other than the Lone Star tick, though others have been known to carry it too.
According to the CDC, the incubation period for a case of Ehrlichiosis takes between 5 to 14 days. Once the infection takes hold, hosts can experience any number of different symptoms, including fever, chills, malaise, headache, stomach pain, and rash. Most cases can be treated with a strong course of antibiotics. Though most cases are mild, the side effects from more intense cases can be severe.
Those with pre-existing conditions, such as HIV, cancer, and other immunosuppression cases, are at an increased risk of having severe complications arising from an Ehrlichiosis infection. These complications include brain damage, hemorrhaging, heart failure, respiratory failure, kidney failure, and septic shock.
Alpha-gal syndrome
Alpha-gal syndrome is an aggravating infection that has the potential to cause life-threatening allergic reactions. This is caused primarily by the Lone Star tick, which passes along a sugar molecule, alpha-gal, into the bloodstream of the host. In some, the presence of alpha-gal won't do anything at all. For others, however, it can cause severe allergies to a number of different, well-loved foods.
Alpha-gal syndrome can create allergies to red meats like beef, pork, and lamb, though not to poultry or fish, per The Mayo Clinic. The allergies can also extend to animal-based dairy and gelatin products, making one's eating options severely limited.
Alpha-gal is tricky because it doesn't present itself right away like other food allergies do. According to the American Academy of Allergy, Asthma, and Immunology, symptoms won't tend to appear until several hours after eating. Mild reactions include hives, coughing, swelling, abdominal pain, and diarrhea. More severe cases can cause anaphylaxis, which, as anyone with a severe allergy knows, can be fatal.
Borrelia Miyamotoi disease
Invasive species, be they birds or insects, won't just adversely affect gardens. In the case of ticks, they can wreak havoc on people by spreading diseases such as Borrelia Miyamotoi. The bacteria that causes this disease is distantly related to the one that causes Lyme disease. The difference is that while Lyme is caused by native American ticks, Borrelia Miyamotoi was brought over by Japanese ticks. First discovered in the early 1990s, the disease gradually made its way from Japan over to the United States, where the bacterium has been transferred to American black-legged ticks and Western black-legged ticks.
Among the more mild of the diseases in this list, most cases of Borrelia Miyamotoi cause not much more than mild, flu-like symptoms such as low-grade fever, chills, headache, and mild joint pain. Rashes are also possible, though they are highly uncommon.
This bacteria can cause a phenomenon known as Tick-Borne Relapsing Fever. As it sounds, this follows a pattern of symptomatic fever periods, followed by a break, followed by a relapse, per the CDC. If the host does not receive antibiotic treatment, these relapses are likely to continue for the rest of the host's life.
Tularemia
Undoubtedly the most outwardly grizzly of the diseases on this list, Tularemia, also known as rabbit fever, was first discovered in small rodents, per the CDC. The ticks that tend towards the smaller mammals are those same nymph-stage ticks that cause Babesiosis. Likewise, Tularemia might be passed along without the host even realizing it until the symptoms start to present themselves. When they do show up, things can get rather nasty.
Caused by the Francisella tularensis bacteria and found in every U.S. state, Tularemia symptoms are typically aches, fever, chills, and stomach issues. However, Tularemia has several different presentations that occur in tandem with these symptoms. A few examples are ulceroglandular form, which accounts for 80% of all cases and causes skin ulcers, and the oculoglandular form, which causes swollen glands and painful discharge from the eyes, via the Illinois Department of Health.
Untreated Tularemia has a 5% to 15% mortality rate, which drops to around 1% if the proper antibiotics are taken. The characteristic ulcers the disease leaves behind will heal, though they may take their sweet time.
Bourbon virus
Only recently discovered in Bourbon County, Kansas, in 2014, the Bourbon virus is among the more newfangled tick-borne illnesses that researchers are still trying to learn as much about as they can. Not a bacterium like other diseases on this list, the Bourbon virus cannot be treated with antibiotics. Thankfully, the CDC notes that symptoms of the Bourbon virus seem to be on the milder side, with the usual flu-like symptoms such as fever, aches, and chills. More seriously, the Bourbon virus can drastically lower white blood cell counts and platelets, opening a host up to a number of potentially different issues down the road.
Passed along by the Lone Star tick, and now endemic throughout the midwest and eastern United States, Bourbon virus cases have been increasing steadily. As researchers learn more about what kinds of local animals carry this virus, they will be able to locate better the various types of ticks that pass the disease along.
Almost all of these diseases can be prevented if the proper treatment is taken and preventive measures are put in place before one decides to trek out into the woods. Not all tick bites will yield these diseases, but they are prevalent enough to be of concern. Again, if you experience any of the symptoms we've listed in this article, see your doctor right away.